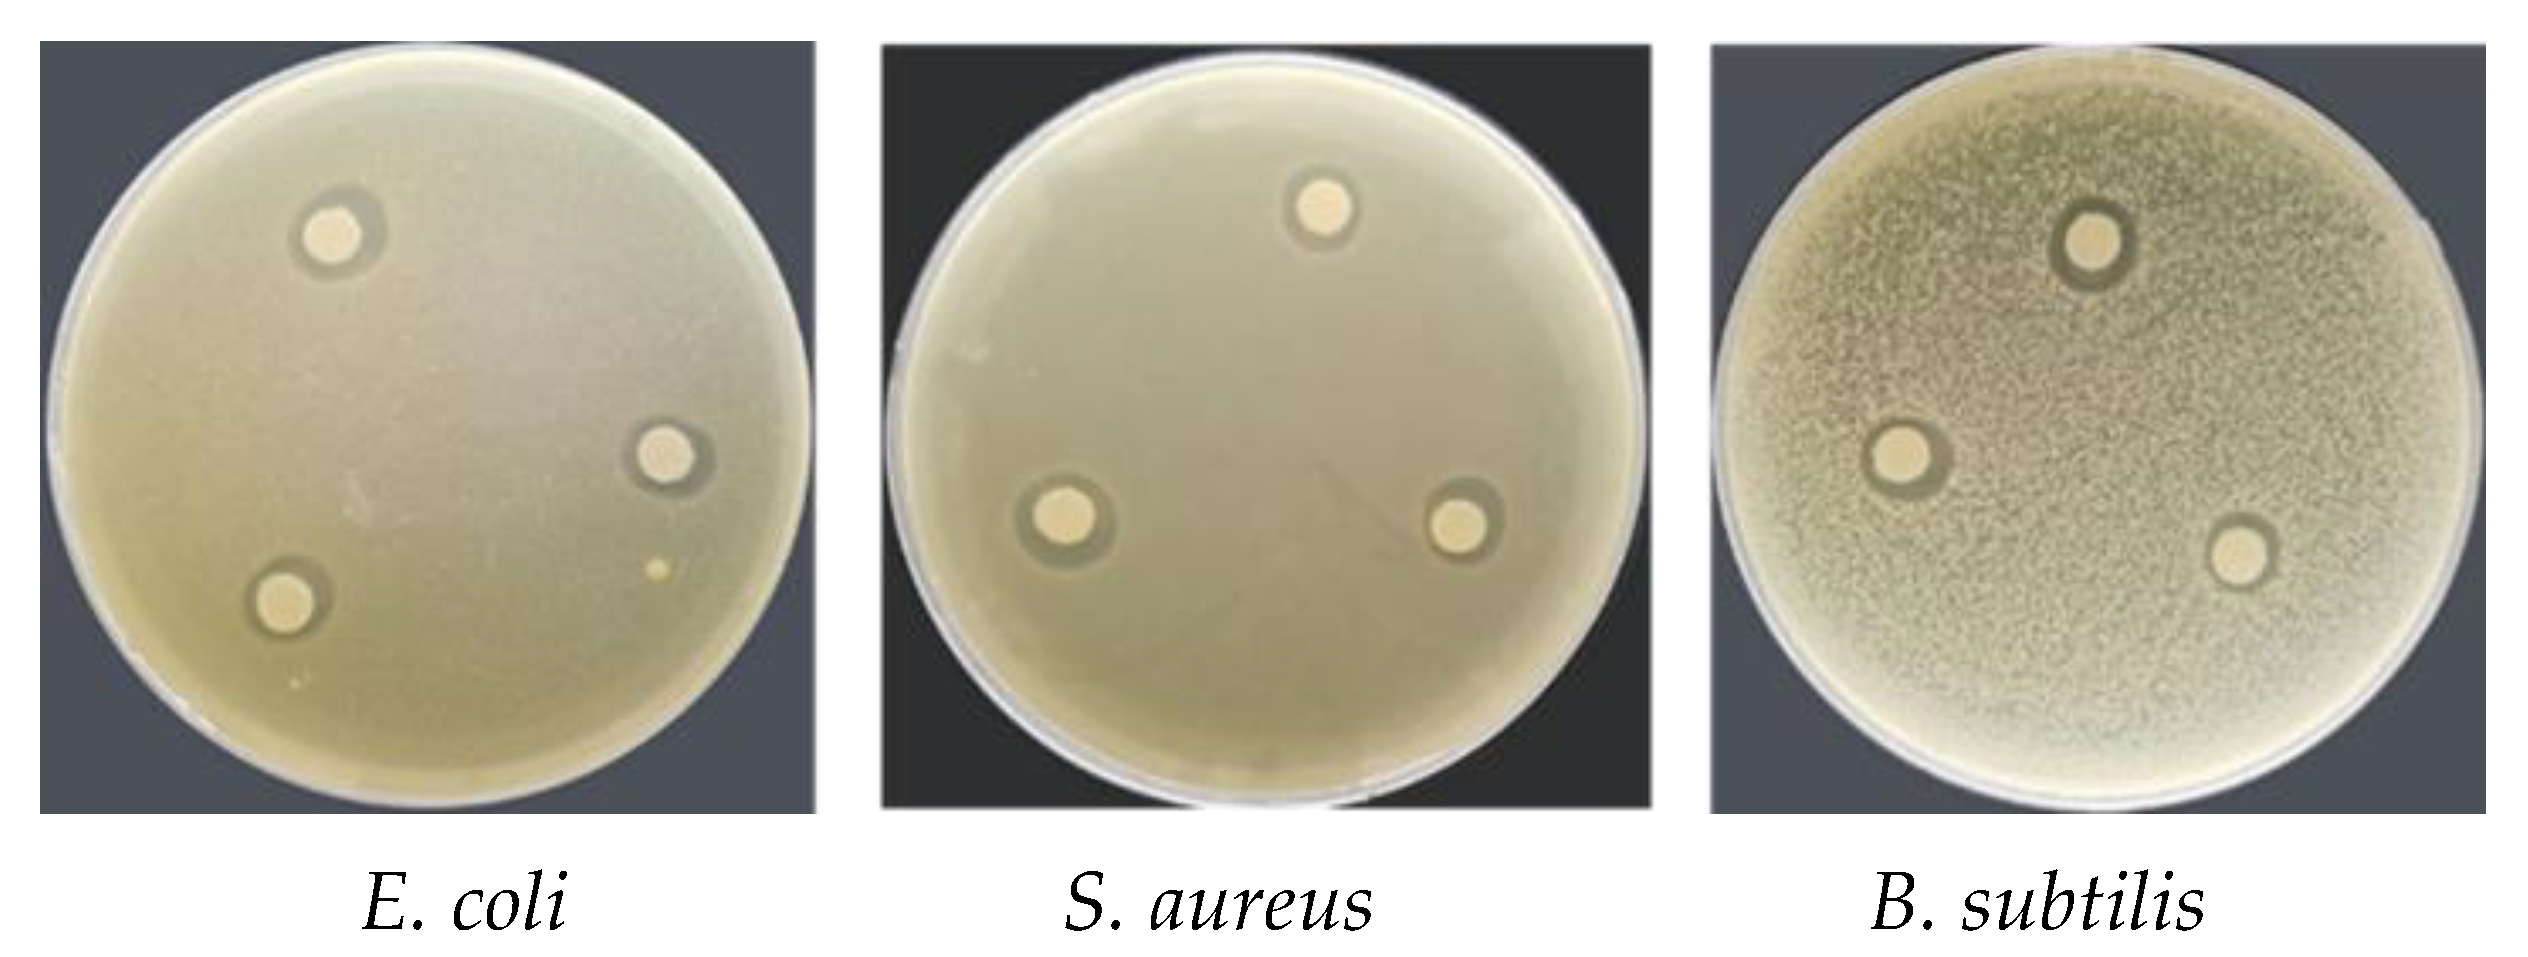
Coatings 12 00254 g007

Abstract
Essential oils are natural antibacterial substances and have potential value for application in fruit and vegetable packaging. In this study, Chinese fir essential oil (CFEO) was microencapsulated to prepare food packaging materials for the first time to overcome its volatilization and oxidation shortcomings and to obtain a sustained-release form of the oil. CFEO was effectively encapsulated in gelatin and chitosan using the complex coacervation method, and the encapsulation efficiency, microstructure, infrared spectrum and thermal stability of the microcapsules were evaluated. Experiments confirmed that the microcapsules had some antibacterial activity. A bioactive paper was developed by combining CFEO microcapsules (CFEO-Ms) with paper-based material using the film-forming property of polyvinyl alcohol (PVA). The coated paper showed good mechanical, air permeability and moisture permeability properties. Environmental scanning electron microscopy confirmed that CFEO-Ms bonded well with PVA and was successfully introduced into the paper fiber after coating, forming an obvious coating film on the surface to facilitate the continuous release of CFEO. The shelf life of strawberries was significantly prolonged when the PVA-coated paper mixed with 3% CFEO-Ms was used for packaging. The results demonstrated that the CFEO-Ms coated paper has the potential to become an effective packaging material for the preservation of strawberries.
1. Introduction
Plant essential oils obtained from the flowers, leaves, roots, bark, fruits and seeds of aromatic plants via distillation or physical pressing are highly concentrated extracts that are natural products with environmentally friendly characteristics [1]. Plant essential oils have antibacterial, antimicrobial, anti-insect and antivirus properties and are widely used in fields that include anticorrosion, preservation, medicine, health care and the chemical industry [2,3]. Different types of essential oil have been studied worldwide, including ginger essential oil [4], Angelica essential oil [5], lavender essential oil [6], vetiver essential oil [7], cinnamon essential oil [8] and Chinese fir essential oil [9,10] (CFEO, similar purpose with Tarragon Essential Oil [11,12]), with some results showing that plant essential oils can be used as active substances in packaging materials to prolong food shelf life effectively. Compared with other essential oils, CFEO is derived from wood, which has a pungent woody aroma and lacks fragrance. Most of the research on CFEO has focused on the analysis of the mechanisms underlying its antibacterial activity, but applications are rarely reported. The raw material for CFEO—Chinese fir (Cunninghamia lanceolata)—is an essential commodity in China that is widely used in construction, bridges, shipbuilding, furniture and appliances [13,14,15,16]. There is no research on the use of CFEO in food packaging paper, an area for which CFEO has the potential to be used as a natural preservative in packaging materials for food preservation in the future; however, CFEO applications have been restricted by its limitations, which include insolubility in water, poor stability, volatilization and oxidation [17]; therefore, there is an urgent need to explore solutions to the above limitations to expand the application of CFEO in food packaging.
Microcapsule technology involves the use of one or more polymer film-forming materials (wall material) to embed a solid, liquid or gas (core material) to form a microsized capsule that protects the core material [18]. Microencapsulation can control the release of volatile substances and can also improve the hydrophilicity of plant essential oils, protect the composition of sensitive core material and mask bad flavors and colors to solve issues in the application of plant essential oils in foodstuffs [19]. Several methods for microcapsule preparation have been proposed, such as spray drying [20], complex coacervation [21], layer self-assembly [22] and Pickering emulsion templates [23]. When oppositely charged polyelectrolytes are present together in a solution, a dense coacervated phase can be formed via electrostatic interaction under appropriate conditions [24]. This process is termed complex coacervation, which has the characteristics of high yield, high efficiency and low influence on the biological activity of the oil-soluble core material under mild conditions [21,25].
As the shell surrounding the core material, the microcapsule wall can effectively protect the release of the core material and improve its stability [26]. Plant essential oil microcapsules are mostly made of natural polymer materials that are biodegradable and biocompatible [27]. Biopolymer systems comprising natural polysaccharides and proteins are the most common combinations for wall materials and provide a safe substrate for food packaging [28]. Gelatin has good solubility, emulsification and gelation, and is one of the most ideal microcapsule wall materials [29]. Chitosan is also widely used as a microcapsule wall material because of its excellent biocompatibility, antibacterial action, biodegradability, safety and wide availability [30].
At present, nondegradable plastic packaging for food poses a threat to environmental safety. Biodegradable polymers with good mechanical properties and low permeability are very important materials in food packaging [31]. Recently, PVA has attracted more and more attention from researchers for biomedical applications such as eye drops, contact lenses, tissue adhesion barriers and artificial cartilage, owing to its unique properties, including biocompatibility, hydrophilicity, nontoxicity and biodegradability. It also has outstanding film-formation characteristics [32,33]. Because of this property, coupled with excellent chemical stability and hydrophilicity, it is blended with a variety of synthetic and natural polymers such as a water-soluble film and is used in food packaging [34]. Among biodegradable polymers, polyvinyl alcohol (PVA) has attracted much attention because of its excellent film-forming ability [35]; however, PVA film is also highly hydrophilic and water-soluble, so its application in packaging is limited [36]; therefore, a modified PVA was adopted in this study to improve the water resistance of the packaging material.
In this study, gelatin and chitosan were used as wall materials to prepare CFEO microcapsules (CFEO-Ms) using a complex coacervation method. The encapsulation efficiency, antibacterial activity, particle morphology, thermal stability and infrared spectrum of the microcapsules were evaluated. In addition, PVA was used as a film-forming matrix to prepare paper coated with CFEO-Ms for food packaging. The preservation effect of CFEO-Ms during strawberry storage was evaluated. Taking strawberries as an example for preservation, the effect of CFEO-Ms-coated paper on strawberry preservation is discussed. Compared with other studies, this paper did not study the antibacterial mechanism of CFEO and the infrared spectrum analysis of the coated paper. Follow-up experiments can be further explored.
2. Materials and Methods
2.1. Materials
Chitosan (BR, deacetylation degree 80%–95%) and gelatin (CP, Type B, Bloom No. 250) were supplied by Sinopharm Chemical Reagent Co., Ltd., Shanghai, China. CFEO was supplied by Anhui Hanfang Biotechnology Co., Ltd., Huangshan, China. Sodium hydroxide (AR) was purchased from Nanjing Chemical Reagent Co., Ltd., Nanjing, China. Glacial acetic acid (AR) was obtained from Shanghai Jiuyi Chemical Reagent Co., Ltd., Shanghai, China. Glutaraldehyde (AR) was purchased from Aladdin, Shanghai, China. Staphylococcus aureus (ATCC6538), Escherichia coli (ATCC25922) and Bacillus subtilis (ATCC6633) were obtained from Shanghai Luwei Bio-Technology Co., Ltd., Shanghai, China. Lysogeny broth (LB) was prepared at the Biological Laboratory, Nanjing Forestry University, Nanjing, China. Glycerol (AR, 99%) and Tween 80 were purchased from Shanghai Macklin Biological Co., Ltd., Shanghai, China. PVA was provided by Anhui Wanwei High-tech Materials Co., Ltd., Chaohu, China
2.2. Preparation of CFEO-Ms
CFEO-Ms were prepared via complex coacervation using gelatin and chitosan as wall materials. Typical steps in microencapsulation of essential oil by complex coacervation process involve: (i) emulsification; (ii) electrostatic attraction; (iii) wall formation; (iv) wall hardening [37]. After optimization in preliminary tests, the following preparation method was used. A 0.5% chitosan solution (Solution A) was prepared by dissolving 0.1 g of chitosan in 20 mL of 1% acetic acid. To prepare Solution B, 1 g of gelatin was mixed with 200 mL of distilled water and the mixture was stirred (DF-101S, Shanghai Lichen Bangxi Instrument Technology Company, Shanghai, China) at 50 °C for 30 min until all the gelatin was completely dissolved. Then 0.37 g of CFEO and Tween 80 at a ratio of 2:1 were added to the system. Solution B was emulsified (GBP-USC201L, CSIC715, Hangzhou, China) at 700 W for 5 min to create a uniform mixture. Solution A was slowly dispersed into Solution B via mechanical stirring at 500 rpm at 50 °C for 30 min. Then the pH was adjusted to 5.4 with 5% sodium hydroxide at room temperature and stirring was continued for 1 h. The reaction system was cooled to below 10 °C in an ice bath, then 0.5 mL glutaraldehyde was added dropwise over a period of 30 min. A microcapsule suspension was obtained after stirring continuously for 4 h. Finally, the suspension was washed, centrifuged and dried to obtain microcapsule powder.
2.3. Determination of the CFEO-Ms Encapsulation Efficiency
A full-wavelength scan of diluted CFEO was performed to determine its maximum absorption wavelength. Different CFEO concentrations (0.01–0.08 mg L−1) were prepared to obtain a standard curve.
Microcapsules (0.5 g) were dissolved in 50 mL of anhydrous ethanol, soaked for 1 h and then treated with ultrasound for 30 min. The treated samples were centrifuged at high speed for 10 min and the absorbance of the supernatant at maximum absorption wavelength (208 nm) was measured. The CFEO-Ms loading capacity was calculated using a standard curve. The encapsulation efficiency was calculated using Equation (1) [38] and the experiment was carried out in triplicate.
2.4. Particle Size
The particle size distribution of microcapsules was determined using a dynamic light-scattering laser particle size analyzer (BT-90, Baxter Instruments Company, Hangzhou, China).
2.5. Optical Microscopy Observations
The microcapsule emulsion was diluted several times, one drop was placed on a slide, a cover slip was used to disperse the droplet evenly and the structure was observed under a microscope (Dimension Edge, Bruker, Karlsruhe, Germany).
2.6. Thermogravimetric Analysis
The thermal stability of samples was measured via thermogravimetric analysis (TGA; 209 F1, Netzsch, Selb, Germany). A sample of 8 mg was weighed and put into the TGA furnace. The temperature was increased from 30 to 700 °C at a constant rate of 20 °C/min, with nitrogen at a flow rate of 20 mL/min as the protective gas.
2.7. Fourier-Transform Infrared Spectroscopy
Fourier-transform infrared (FTIR) spectra of chitosan, gelatin, CFEO and chitosan-gelatin microcapsules were recorded (VERTEX 80 V, Bruker, Ettlingen, Germany). Each sample was scanned 16 times at a resolution of 4 cm−1 in the wave number range from 4000 to 500 cm−1.
2.8. Antimicrobial Effects of CFEO-Ms
Staphylococcus aureus (S. aureus), Escherichia coli (E. coli) and Bacillus subtilis (B. subtilis) were selected as test bacteria to explore the antibacterial activity of CFEO-Ms using the agar diffusion method [39]. An aliquot of microcapsule emulsion was centrifuged to half its original volume. Filter paper (d = 6 mm) was soaked in the liquid so that the microcapsule material was evenly distributed on the surface of the filter paper. The filter paper was placed on LB medium (d = 90 mm) mixed with bacterial suspension and agar (55 °C) and incubated at 37 °C for 24 h. The diameter of the inhibition zone was measured to judge the antibacterial activity of the microcapsule material.
2.9. Preparation of Coating Solution and Coated Paper
To prepare the coating solution, 6 g of PVA powder was added to 100 mL of distilled water and heated at 90 °C for 30 min with stirring. After cooling to room temperature, 2.4 mL of glycerin was added and stirred at 50 °C for 30 min at the same speed to obtain the coating base solution. CFEO-Ms were added to the base solution at different concentrations (1%, 2% and 3%) under stirring for 2 h to evenly distribute the microcapsules in the system and were kept at room temperature for later use. Paper was fixed at one end of the coating roller of a multifunctional coating machine (K303, RK Print Coat Instruments Ltd., Litlington, UK). A certain amount of coating liquid was placed in the coating machine and was evenly applied to the paper. Paper samples coated with PVA/CFEO at microcapsule concentrations of 0%, 1%, 2% and 3% were then dried at 40 °C for 5 min in an oven, and are denoted as P0, P1%, P2% and P3%. In addition, uncoated paper was used as a comparison in experiments. To normalize the moisture content of the paper, uncoated paper and coated paper were equilibrated in an environment at constant temperature and humidity.
2.10. Surface Characterization
The appearance of microcapsules and coated paper was imaged via environmental scanning electron microscopy (ESEM; Quanta 200, FEI, Hillsboro, OR, USA) and the morphology was observed at acceleration voltages of 2.0 and 15 kV, respectively.
2.11. Physical Properties of Coated Paper
Grammage was determined as described in the standard method ISO 536, where 10 samples of each paper were cut into size 10 cm × 10 cm and weighed. The coated paper thickness was measured with a thickness meter (J-DHY03A, Changjiang Paper Instrument Co., Ltd., Sichuan, China) at 10 random locations on each paper in accordance with the ISO 534, and the average value of the results was taken.
The oxygen resistance of coated paper was evaluated by measuring the oxygen permeability (VAC-V1, Jinan Blu-ray Electromechanical Co., Ltd., Jinan, China) of samples at 30 ± 2 °C and 60% relative humidity (RH). The upper and lower cavities of the instrument were degassed for 10 h and samples were tested after the upper chamber pressure stabilized. The average value for three parallel samples was used as the final result.
The influence of the microcapsule concentration on the water vapor transmittance of coated paper was investigated. The water vapor permeability (WVP) of paper coated with different microcapsule concentrations was measured using a gas permeability tester at 38 °C and 70% RH (W3/060, Jinan Blu-ray Electromechanical Co., Ltd.). The sample was tested for 15 min in triplicate and the average of the three tests was used as the result.
2.12. Mechanical Properties of Coated Paper
Samples were equilibrated at constant temperature and humidity for 2 days. A paper flexural tester (YQ-Z-31, Changchun Yueming Small Experimental Machine Co., Ltd., Changchun, China) and paper tension instrument (WZL-300, Hangzhou Light Tong Instrument Development Co., Ltd., Hangzhou, China) were used to evaluate the mechanical properties of samples from each experimental group. Experiments were carried out at 23 °C and 50% RH under controlled conditions. Rectangular samples (15 mm × 100 mm) were cut from each type of paper for testing. Experiments were performed 10 times for each group and the average value was taken.
2.13. Quality Parameters of Strawberries
2.13.1. Weight Loss
The weight loss for strawberries during storage was determined using the difference method. Strawberries were weighed on the initial and sampling days and the following Formula (2) [40] was used to calculate the weight loss:
where m0 is the initial weight of the strawberries and m1 is the weight on the sampling day.
2.13.2. Decay Percentage
Twenty strawberries were randomly selected from each group and the surface decay of strawberries was observed on the sampling day. The Formula (3) [41] for calculating the decay percentage is as follows:
where nr is the number of decayed strawberries and n0 is the total number of strawberries.
2.13.3. Firmness
Strawberry firmness was measured using a GY-2 fruit hardness tester (Suzhou Qile Electronic Technology Co., Ltd., Suzhou, China). Before measurement, approximately 1 cm2 of the epidermis on the surface of a strawberry was peeled off. During measurements, the cylindrical probe (φ = 3.50 ± 0.02 mm) at the bottom of the hardness tester was placed perpendicular to the surface of the strawberry and evenly pressed into the fruit until it stopped at 10 mm on the scale line. The average of the three measurements was taken as the firmness result.
2.13.4. Soluble Solids Content
The soluble solids content (SSC) of strawberry was determined using a refractometer (JHGXL/T-32ATC, Chzhou Jiuhua Optical Instrument Co., Ltd., Guangzhou, China). Strawberry juice was dropped on the detection prism, the cover plate was closed (making sure that there were no residual bubbles) and the instrument was aligned with the light source for reading. The scale value on the dividing line indicates the concentration of the solution.
2.14. Statistical Analysis
All statistical analyses were conducted using Origin software (version: OriginPro 2021b (64-bit) SR2 9.8.5.21, IBM, Chicago, IL, USA) and results are expressed as the mean ± standard deviation. One-factor analysis of variance was used to compare the different treatments. The Duncan test was used to determine the significance of differences between groups at a significance level of p < 0.05.
3. Results and Discussion
3.1. Characterization of Chitosan–Gelatin Microcapsules
3.1.1. UV Standard Curve for CFEO
A UV spectrophotometer (Tu-1900, AOE Instruments, Shanghai, China) was used to measure the absorbance of different CFEO concentrations at 208 nm. The standard curve obtained is shown in Figure 1. It was evident that the CFEO concentration was linearly correlated with the peak area at 208 nm according to y = 11.051x + 0.0623, with R2 = 0.9995.

Figure 1.
UV standard curve for CFEO.
3.1.2. Particle Size Distribution of the Microcapsules
The particle size distribution of CFEO-Ms prepared via complex coacervation is shown in Figure 2. It was evident that the microcapsule particle size was in the range 111−250 nm and exhibited a normal distribution.

Figure 2.
Particle size distribution of the CFEO-Ms.
3.1.3. Morphology
Figure 3 shows a microscopy image of CFEO-Ms. Most of the microcapsules in the image were clustered, which maybe because of the low dilution ratio and poor dispersion. It was apparent from the small number of particles of large size that the microcapsules prepared had a multinuclear structure and thick capsule wall, which can better control the release of the core CFEO and play a role in its sustained release.

Figure 3.
Micrographs of the CFEO-Ms.
3.1.4. Microcapsule Structure Analysis
The surface structure of the CFEO-Ms is shown in Figure 4. The microcapsules had a spherical surface morphology. This was because glutaraldehyde can react with nitrogen atoms on the amide and amine groups of gelatin and chitosan to form covalent bonds [42], thus enhancing the gel network of the capsule material. Meanwhile, covalent cross-linking reduced the swelling of microcapsules dispersed in distilled water. In addition, cross-linking protected the integrity of the capsule wall during freeze-drying, thus maintaining the integrity of cross-linked microcapsules [43].

Figure 4.
ESEM images of CFEO-Ms at magnification of (a) 10,000× and (b) 20,000×.
3.1.5. Thermal Stability
TGA is an important measure for evaluating the thermal stability of materials. Figure 5 shows TGA and derivative thermogravimetric (DTG) curves for microcapsules, CFEO, chitosan and gelatin. The temperature at which initial weight loss occurred for the microcapsules was about 100 °C, which may be attributable to the loss of residual water in the microcapsules [44]. At this temperature, CFEO also began to decompose up to approximately 179 °C, with a high weight loss of 98.72%, indicating that the core material was volatile. Another weight-loss event (~50%) was observed for the microcapsules between 250 and 400 °C. This may be related to self-degradation because of the instability of the microcapsules in this range: as the temperature rises, the covalent bonds formed via electrostatic attraction between gelatin and chitosan are destroyed and the core material is constantly released [45]. It has been reported that gelatin decomposes at 275–375 °C and that the wall material also decomposes gradually [46]. During the final TGA stage (400–600 °C), the weight loss from the microcapsules was approximately 15%. In this temperature range, the core material had been completely released and the weight loss can be attributed to the decomposition of the wall material; therefore, the results indicated that CFEO was successfully encapsulated in the wall material and that the microcapsule structure improved the stability of the core material at high temperature.

Figure 5.
TGA (a) and DTG (b) curves for CFEO, chitosan, gelatin and CFEO microcapsules.
3.1.6. FTIR Analysis
FTIR is the main technique used to determine the molecular structure of proteins, polysaccharides and drugs [47]. Thus, FTIR analysis was used to confirm the compatibility of gelatin and chitosan for microencapsulation in terms of intermolecular interactions between –NH2 and –COO– groups. Figure 6 shows FTIR spectra for CFEO, chitosan, gelatin and CFEO-Ms. The characteristic absorption peaks for gelatin can be attributed to amino N–H stretching vibrations (3426 cm−1), alkyl C–H stretching vibrations (2930 cm−1), C–N stretching vibrations for atoms in the amide bond (1243 cm−1) and amide carbonyl C=O stretching vibrations (1635 cm−1). The characteristic peaks for chitosan were at 3430 cm−1, 2947 cm−1 and 1648 cm−1, corresponding to –OH and –NH2 stretching vibrations, C–H stretching vibration and characteristic amide absorption, respectively. The hydroxyl (–OH), amine (–NH2) and carboxylate (–COO–) groups in gelatin could form hydrogen bonds with –OH and ammonium (–NH3+) in chitosan [48]. In the FTIR spectrum for CFEO, peaks at 2934 cm−1 and 2869 cm−1 can be attributed to –CH2 stretching vibrations, while the peaks at 1450 cm−1 and 1372 cm−1 are due to –CH3 stretching vibrations. It is known that the main component of CFEO is cedrene. The peaks for CFEO at 1640 cm−1 and 884 cm−1 can be assigned to C=C stretching vibrations and =CH bending vibrations, respectively. The FTIR spectrum for CFEO-Ms contained characteristic CFEO absorption peaks, from which it can be hypothesized that CFEO contained within the microcapsules retained its chemical structure; however, the absorption peaks were significantly weaker. This was because infrared vibration peaks for CFEO were limited and intermolecular forces were weakened after microencapsulation, so the results confirmed that CFEO was successfully encapsulated by the wall material.

Figure 6.
FTIR spectra: a = gelatin; b = CFEO microcapsules; c = chitosan; d = CFEO.
3.1.7. Antimicrobial Activity
The antibacterial effects of CFEO-Ms on E. coli, S. aureus and B. subtilis are shown in Figure 7. It was evident that CFEO-Ms had a significant antibacterial effect on the three species. The average diameter of the antibacterial zone was 12.1, 11.8 and 10.9 mm, respectively, with no significant difference between the bacteria. Mei et al. [49] results show that Gram-positive bacteria are more sensitive to CFEO than Gram-negative bacteria. The difference in results may be related to the essential oil composition. Relevant studies [10,50] show that the main components of CFEO differ according to the extraction method and the tree parts used. The main components of the CFEO used in this study were cedarwood and α-cedrene. A synergistic effect between them may contribute to the CFEO antibacterial activity to some extent. Further study is needed to elucidate the mechanism underlying the antibacterial effect.

Figure 7.
Antibacterial effect of CFEO-M on E. coli, S. aureus and B. subtilis.
3.2. Characterization of Coated Paper
3.2.1. Surface Morphology
The effect of coating on paper morphology was observed using ESEM. Figure 8 shows ESEM images of uncoated paper and the four coated papers (P0, P1%, P2% and P3%). It was apparent that the uncoated paper had a porous network structure with an irregular arrangement of fibers. After coating with the PVA base solution (P0), the paper surface was covered with PVA evenly distributed on the fibers, forming a dense film structure. According to results for oxygen permeability and WVP, the coated paper had good barrier properties. For the coating solutions containing CFEO-Ms, as the CFEO-Ms concentration increased, microcapsule agglomeration occurred on the paper surface (Figure 8d,e) and PVA film formation weakened. This was consistent with the permeability results in Table 1.

Figure 8.
Scanning electron micrographs of (a) uncoated paper, (b) P0, (c) P1%, (d) P2% and (e) P3% at 400× magnification.

Table 1.
Weight, thickness, OTR and WVP of uncoated and coated paper.
3.2.2. Physical Properties
Table 1 lists results for the grammage, thickness and permeability of uncoated, PVA-coated and PVA-CFEO-Ms (PVA-Ms)-coated papers. The grammage and thickness of the base paper were 45 g/m2 and 60.6 μm, respectively. The grammage and thickness of the coated papers increased uniformly on the addition of increasing CFEO-Ms concentrations to the coating solution, which confirmed the effectiveness of the coating formation [51].
The oxygen permeability is the volume of oxygen passing through a unit area of the sample in 24 h under a pressure difference of 0.1 Mpa [52]. It can be seen from Table 1 that the oxygen permeability of coated papers first decreased and then increased with increasing CFEO-Ms concentration. When the CFEO-Ms concentration was increased from 0 to 1 g/100 mL, the permeability decreased from 30.97 to 1.82 cm3 m−2 d−1 0.1−1 Mpa−1, a decrease of 94.12%. When the CFEO-Ms concentration was increased to 3 g/100 mL, the oxygen permeability reached 96.25 cm3 m−2 d−1 0.1−1 Mpa−1, an increase of 67.82%. The reason may be that the thickness of the CFEO-Ms layer on the coated paper surface increased with the concentration in the coating solution, which would extend the diffusion path for gas molecules in the film [53]. The surface structure of the paper confirmed this. Figure 8 shows that the surface of the uncoated paper is porous and the surface of PVA-coated paper is smooth. The addition of microcapsules and PVA forms a denser film covering the surface of P1% coated paper. At the same time, if a small number of microcapsules were added, these could combine with the PVA film matrix to form a denser microcapsule film, so that the coated paper would have a better barrier effect; however, excessive CFEO-Ms addition may lead to agglomeration of microcapsules in the PVA matrix, resulting in poor bonding in the interface between the two phases and thus facilitating the diffusion of gas molecules in the film matrix and a significant increase in oxygen permeability.
WVP is the ability of water to penetrate and pass through a material [54]. Water plays an important role in fruit quality and stability [55]. Permeability results for uncoated paper, CFEO-Ms-coated paper and PVA-coated paper are shown in Table 1. The permeability of uncoated paper exceeded the measurement range of the instrument. Overall, WVP was lower for the PVA-Ms paper than for paper coated without CFEO-Ms. This may be because CFEO-Ms addition changed the network structure during film formation and more hydroxyl groups were cross-linked, leading to a decrease in the density of the film structure [56]. At the same time, the tortuosity of the water vapor diffusion path increased on CFEO-Ms addition. Moreover, the free space volume of the system increases as the CFEO-Ms concentration increases and the paper surface will become loose and porous, so the permeability will also increase.
3.2.3. Mechanical Properties
The influence of CFEO-Ms addition on the mechanical properties of coated paper was investigated in terms of the folding strength and tensile strength. Folding strength is the capability that paper resists repeated folding, while tensile strength is the tension that paper can withstand [57,58]. Considering the anisotropy of paper, two measurement directions (machine direction and cross-machine direction) were used. In general, the longitudinal mechanical properties of paper are greater than its transverse mechanical properties [59]. It was evident from Figure 9a that the folding strength in the vertical and horizontal directions conforms to this observation. In comparison to the uncoated paper, the folding strength of coated paper was significantly affected by the coating layer and its folding strength was also significantly improved. As the CFEO-Ms concentration was increased, the folding strength of the coated paper also increased, indicating that CFEO-Ms addition improved the affinity between the PVA and the paper fibers. The greater the CFEO-Ms concentration, the stronger was the adhesion between the fibers and PVA, increasing the folding strength of the paper.

Figure 9.
Folding strength (a) and tensile strength (b) of uncoated paper, PVA-coated paper and paper coated with PVA-CFEO-Ms at different concentrations. Data are expressed as the mean ± standard deviation (n = 3). Different letters on the diagram indicate significant differences between groups at p < 0.05. CD = machine direction; MD = cross-machine direction.
Figure 9b shows tensile strength results for the different samples. According to the overall trend, CFEO-Ms addition improved the tensile strength of coated paper, regardless of the measurement direction. The reason may be that infiltration of the coating liquid into paper fibers and spaces between fibers enhanced the binding force between fibers [60]. Second, CFEO-Ms were evenly dispersed in the PVA film matrix, leading to an orderly arrangement of PVA molecules [61]. Moreover, the large specific surface area for CFEO-Ms promoted the binding of the microcapsules to the PVA film [62].
3.2.4. Weight Loss
Strawberries have a high water content and water loss during storage can cause wrinkles [63]. The weight loss of strawberry is an important index that reflects respiration rate and moisture evaporation between the fruit tissue and surrounding air. As shown in Figure 10a, the weight loss of strawberries increased with the storage time. After 7 days of storage, strawberry weight in the control, P0 and P3% groups decreased by 45.31%, 39.43% and 24.31%, respectively. The data trend suggested that coated paper played an important role as a water barrier between the strawberries and the environment during storage. Moreover, the presence of CFEO-Ms in PVA-coated paper inhibited microorganism growth on the strawberry surface, reduced the respiration rate of the fruit and better-retained water within the strawberries, resulting in a lower rate of weight loss [64].

Figure 10.
Effects of coated and uncoated paper on percentage decay (a), weight loss (b), firmness (c) and soluble solids content (d) during strawberry storage at room temperature.
3.2.5. Percentage Decay
Because of physiological changes, environmental effects and harmful microbial infection, the surface of strawberries gradually softens and decays during storage [65]. Figure 10b shows that on day 2 of storage, fruits in the control and P0 groups showed varying degrees of decay, while those in group P3% were well preserved. On day 4, rotting in the control group intensified and the fruit had no edible value. After storage for 7 days, the percentage decay was 72.85% for the control group, 69.9% for the P0 group and 43.7% for the P3% group. The data showed that CFEO had a preservation effect on strawberries and prolonged their edible date. This may be due to the slow release of CFEO from the microcapsules, which then inhibited the growth of some microorganisms on the strawberry surface. This result was consistent with the appearance of the fruit during storage in Figure 11. These findings suggested that PVA-Ms paper could keep the weight loss of strawberries within a certain range.

Figure 11.
Appearance of strawberries coated with different treatment groups.
3.2.6. Firmness
Fruit firmness plays a significant role in consumer decision-making [66]. As the berries ripen, the flesh gradually softens. As a result, firmness and storability are reduced, which is related to the degradation of fruit pectin and cellular matter [54,67]. Changes in strawberry firmness during storage are shown in Figure 10c. Over the whole storage period, the firmness of strawberries covered with PVA-Ms paper decreased slowly, confirming paper P3% was more effective in maintaining the firmness of the fruit, which was attributed to its better barrier property and mechanical properties that retarded the metabolic activity and water loss of the strawberry [68], and slow down the texture degradation [69]. After 7 days of storage, strawberry firmness was significantly higher than for the control and P0 groups. The firmness of the P0 group decreased significantly on day 4, indicating acceleration of the decomposition rate of pectin by pectinase, and the endurance of the strawberry epidermis and fiber tissue under pressure decreased, further indicating that CFEO-Ms could reduce the degradation rate for strawberry cell materials and minimize water losses.
3.2.7. Soluble Solids Content
The soluble solids in strawberries are a measure of their total sugar content, indicating the degree of ripening and directly affecting the fruit flavor and the degree of consumer acceptance [70,71]. The influence of uncoated and coated papers on strawberry SSC is shown in Figure 10d. It was evident that SSC for the three strawberry samples (control, P0 and P3%) increased gradually with metabolism from day 1 to day 4, indicating that sucrose synthesis occurred in the strawberries during this period [72]. In the later period, SSC decreased with sugar metabolism, especially in the control and P0 groups, which may be because of a faster strawberry respiratory rate in these two groups and the need for more sucrose hydrolysis to maintain physiological activity, resulting in more SSC depletion. Strawberries in the P3% group showed the most stable trend over the whole storage period. On day 7 of storage, SSC was 9.5%, 9.8% and 10.4% for the control, P0 and P3% groups, respectively. The data showed that P3% paper resulted in a higher SSC level at the end of the storage period, which may be because CFEO-Ms-coated paper can slow the metabolism and respiration rate of strawberries to some extent.
4. Conclusions
CFEO-Ms were prepared with gelatin and chitosan as wall materials to encapsulate CFEO and the encapsulation efficiency of microcapsules was 72.24%. ESEM and FTIR results confirmed strong bonding between the two wall compounds. TGA showed that the synthesized microcapsules had good stability. Bacteriostatic experiments demonstrated that the microcapsules had strong antibacterial activity against three species. The combination of CFEO-Ms and PVA enhanced the mechanical properties of the paper and reduced its oxygen permeability and WVP, and the PVA-Ms paper was suitable for packaging fresh strawberries. In comparison to the control group, the firmness, weight and SSC of strawberries covered with P3% were well maintained. The results demonstrated that CFEO-Ms could be used as a natural antibacterial agent to produce coated paper for strawberry packaging materials, inhibit the respiration rate of strawberry and the breeding of microorganisms on the surface, and prolong the shelf life of strawberry. In future research, the physical and chemical properties of the coated paper will be further explored to evaluate the feasibility of food preservation.
Author Contributions
Conceptualization, X.S. and L.S.; Investigation, X.S.; Writing—original draft, X.S.; Project administration, K.Z.; Resources, Q.C.; Supervision, L.S.; Data curation, L.M., S.L. and C.H. All authors have read and agreed to the published version of the manuscript.
Funding
This research was funded by the cinnamon oil raw material forest cultivation and aroma oil deep processing technology integration and demonstration project (2018YFD0600405), Jiangsu Co-Innovation Center for Efficient Processing and Utilization of Forest Resources, Nanjing Forestry University.
Institutional Review Board Statement
“Not applicable” for studies not involving humans or animals.
Informed Consent Statement
“Not applicable” for studies not involving humans.
Data Availability Statement
The data presented in this study are available in the article.
Conflicts of Interest
The authors declare no conflict of interest.
References
- Pavlić, B.; Teslić, N.; Zengin, G.; Đurović, S.; Rakić, D.; Cvetanović, A.; Gunes, A.; Zeković, Z. Antioxidant and enzyme-inhibitory activity of peppermint extracts and essential oils obtained by conventional and emerging extraction techniques. Food Chem. 2021, 338, 127724. [Google Scholar] [CrossRef]
- Esmaeili, Y.; Paidari, S.; Baghbaderani, S.A.; Nateghi, L.; Al-Hassan, A.A.; Ariffin, F. Essential oils as natural antimicrobial agents in postharvest treatments of fruits and vegetables: A review. J. Food Meas. Charact. 2021, 16, 507–522. [Google Scholar] [CrossRef]
- Semeniuc, C.A.; Socaciu, M.-I.; Socaci, S.A.; Mureșan, V.; Nagy, M.; Rotar, A.M. Chemometric Comparison and Classification of Some Essential Oils Extracted from Plants Belonging to Apiaceae and Lamiaceae Families Based on Their Chemical Composition and Biological Activities. Molecules 2018, 23, 2261. [Google Scholar] [CrossRef] [Green Version]
- Lee, Y.R.; Shin, H.S. Effectiveness of Ginger Essential Oil on Postoperative Nausea and Vomiting in Abdominal Surgery Patients. J. Altern. Complement. Med. 2017, 23, 196–200. [Google Scholar] [CrossRef]
- Tabanca, N.; Gao, Z.; Demirci, B.; Techen, N.; Wedge, D.E.; Ali, A.; Sampson, B.J.; Werle, C.; Bernier, U.R.; Khan, I.A.; et al. Molecular and Phytochemical Investigation of Angelica dahurica and Angelica pubescentis Essential Oils and Their Biological Activity against Aedes aegypti, Stephanitis pyrioides, and Colletotrichum Species. J. Agric. Food Chem. 2014, 62, 8848–8857. [Google Scholar] [CrossRef]
- Ahmady, S.; Rezaei, M.; Khatony, A. Comparing effects of aromatherapy with lavender essential oil and orange essential oil on fatigue of hemodialysis patients: A randomized trial. Complement. Ther. Clin. Pract. 2019, 36, 64–68. [Google Scholar] [CrossRef]
- Gautam, M.; Agrawal, M. Application potential of Chrysopogon zizanioides (L.) Roberty for the remediation of red mud-treated soil: An analysis via determining alterations in essential oil content and composition. Int. J. Phytorem. 2021, 23, 1356–1364. [Google Scholar] [CrossRef] [PubMed]
- Tu, Q.-B.; Wang, P.-Y.; Sheng, S.; Xu, Y.; Wang, J.-Z.; You, S.; Zhu, A.-H.; Wang, J.; Wu, F.-A. Microencapsulation and Antimicrobial Activity of Plant Essential Oil Against Ralstonia solanacearum. Waste Biomass-Valorization 2020, 11, 5273–5282. [Google Scholar] [CrossRef]
- Zhang, X.; Zhang, Z.-F.; Ma, Q.-Z.; Deng, H.-P.; Zhang, M.-L. Study on Utilization Value of Pure Natural Medical Resources of Benzene/Ethanol Extractives of Chinese Fir Wood. In Proceedings of the 2009 Symposium on Photonics and Optoelectronics, Wuhan, China, 14–16 August 2009. [Google Scholar]
- Hsu, K.-P.; Su, Y.-C.; Ho, C.-L. Chemical Compositions and In Vitro Antiphytopathogenic Fungi Activities of the Leaf and Cones Essential Oils of Cunninghamia lanceolate from Taiwan. Nat. Prod. Commun. 2020, 15, 15. [Google Scholar] [CrossRef]
- Socaciu, M.-I.; Fogarasi, M.; Simon, E.; Semeniuc, C.; Socaci, S.; Podar, A.; Vodnar, D. Effects of Whey Protein Isolate-Based Film Incorporated with Tarragon Essential Oil on the Quality and Shelf-Life of Refrigerated Brook Trout. Foods 2021, 10, 401. [Google Scholar] [CrossRef] [PubMed]
- Socaciu, M.-I.; Fogarasi, M.; Semeniuc, C.A.; Socaci, S.A.; Rotar, M.A.; Mureşan, V.; Pop, O.L.; Vodnar, D.C. Formulation and Characterization of Antimicrobial Edible Films Based on Whey Protein Isolate and Tarragon Essential Oil. Polymers 2020, 12, 1748. [Google Scholar] [CrossRef] [PubMed]
- Xu, J.; Lie, G.; Xue, L. Effects of gap size on diversity of soil fauna in a Cunninghamia lanceolata stand damaged by an ice storm in southern China. J. For. Res. 2016, 27, 1427–1434. [Google Scholar] [CrossRef]
- Yan, X.; Wang, L.; Qian, X. Effect of Coating Process on Performance of Reversible Thermochromic Waterborne Coatings for Chinese Fir. Coatings 2020, 10, 223. [Google Scholar] [CrossRef] [Green Version]
- Cao, S.; Hu, R.; Wu, X.; Sun, Y.; Wu, B.; Duan, H.; Lin, H.; Wu, M.; Fang, L.; Yu, X.; et al. Two chemical mutagens modulate the seed germination, growth, and phenotypic characteristics of Chinese fir (Cunninghamia lanceolata). J. For. Res. 2021, 32, 2077–2085. [Google Scholar] [CrossRef]
- Li, Y.; Chen, J.; Yang, Y.; Li, C.; Peng, W. Chemical compositions and functions of Chinese fir volatiles. Therm. Sci. 2020, 24, 1853–1859. [Google Scholar] [CrossRef] [Green Version]
- Rao, J.; Chen, B.; McClements, D.J. Improving the Efficacy of Essential Oils as Antimicrobials in Foods: Mechanisms of Action. Annu. Rev. Food Sci. Technol. 2019, 10, 365–387. [Google Scholar] [CrossRef] [PubMed]
- Weitbrecht, K.; Schwab, S.; Rupp, C.; Bieler, E.; Dürrenberger, M.; Bleyer, G.; Schumacher, S.; Kassemeyer, H.-H.; Fuchs, R.; Schlücker, E. Microencapsulation—An innovative technique to improve the fungicide efficacy of copper against grapevine downy mildew. Crop Prot. 2021, 139, 105382. [Google Scholar] [CrossRef]
- Ju, J.; Xie, Y.; Guo, Y.; Cheng, Y.; Qian, H.; Yao, W. Application of starch microcapsules containing essential oil in food preservation. Crit. Rev. Food Sci. Nutr. 2018, 60, 2825–2836. [Google Scholar] [CrossRef]
- Parthasarathi, S.; Anandharamakrishnan, C. Enhancement of oral bioavailability of vitamin E by spray-freeze drying of whey protein microcapsules. Food Bioprod. Process. 2016, 100, 469–476. [Google Scholar] [CrossRef]
- Muhoza, B.; Xia, S.; Wang, X.; Zhang, X.; Li, Y.; Zhang, S. Microencapsulation of essential oils by complex coacervation method: Preparation, thermal stability, release properties and applications. Crit. Rev. Food Sci. Nutr. 2020, 1363–1382. [Google Scholar] [CrossRef]
- Zhang, Z.; Zhang, S.; Su, R.; Xiong, D.; Feng, W.; Chen, J. Controlled Release Mechanism and Antibacterial Effect of Layer-By-Layer Self-Assembly Thyme Oil Microcapsule. J. Food Sci. 2019, 84, 1427–1438. [Google Scholar] [CrossRef] [PubMed]
- Zhang, Z.; Cheng, M.; Gabriel, M.S.; Neto Ângela, A.T.; Bernardes, J.D.S.; Berry, R.; Tam, K.C. Polymeric hollow microcapsules (PHM) via cellulose nanocrystal stabilized Pickering emulsion polymerization. J. Colloid Interface Sci. 2019, 555, 489–497. [Google Scholar] [CrossRef] [PubMed]
- Huang, G.-Q.; Wang, H.-O.; Wang, F.-W.; Du, Y.-L.; Xiao, J.-X. Maillard reaction in protein—Polysaccharide coacervated microcapsules and its effects on microcapsule properties. Int. J. Biol. Macromol. 2020, 155, 1194–1201. [Google Scholar] [CrossRef] [PubMed]
- Gouin, S. Microencapsulation: Industrial appraisal of existing technologies and trends. Trends Food Sci. Technol. 2004, 15, 330–347. [Google Scholar] [CrossRef]
- Veiga, R.D.S.D.; Da Silva-Buzanello, R.A.; Corso, M.P.; Canan, C. Essential oils microencapsulated obtained by spray drying: A review. J. Essent. Oil Res. 2019, 31, 457–473. [Google Scholar] [CrossRef]
- Botrel, D.A.; Vilela Borges, S.; Victória de Barros Fernandes, R.; Dantas Viana, A.; Maria Gomes da Costa, J.; Reginaldo Marques, G. Evaluation of spray drying conditions on properties of microencapsulated oregano essential oil. Int. J. Food Sci. Technol. 2012, 47, 2289–2296. [Google Scholar] [CrossRef]
- Qiang, L.; Li-Jian, S.; Xian-Feng, G.; Yang, W.; Xue-Ling, Z. Simultaneous Optimization of Multiple Response Variables for the Gelatin-chitosan Microcapsules Containing Angelica Essential Oil. Iran. J. Pharm. Res. 2017, 16, 50–62. [Google Scholar]
- Man, L. Preparation and quality evaluation of microcapsules of volatile oil from Ledum palustre. Zhongyaocai 2014, 37, 675–678. [Google Scholar]
- Sargın, I.; Kaya, M.; Arslan, G.; Baran, T.; Ceter, T. Preparation and characterisation of biodegradable pollen–chitosan microcapsules and its application in heavy metal removal. Bioresour. Technol. 2015, 177, 1–7. [Google Scholar] [CrossRef]
- Bui, V.K.H.; Park, D.; Nguyen, M.K.; Moon, J.-Y.; Lee, Y.-C. Preparation of Antimicrobial Aminoclays/Poly(vinyl alcohol) Nanocomposite Hydrogel Films by Freeze-Thawing Method. Macromol. Res. 2019, 27, 523–525. [Google Scholar] [CrossRef]
- Yang, S.B.; Yoo, S.H.; Lee, J.S.; Kim, J.W.; Yeum, J.H. Surface Properties of a Novel Poly(vinyl alcohol) Film Prepared by Heterogeneous Saponification of Poly(vinyl acetate) Film. Polymers 2017, 9, 493. [Google Scholar] [CrossRef] [Green Version]
- Chen, J.; Li, Y.; Zhang, Y.; Zhu, Y. Preparation and characterization of graphene oxide reinforced PVA film with boric acid as crosslinker. J. Appl. Polym. Sci. 2015, 132, 42000. [Google Scholar] [CrossRef]
- Yu, Z.; Li, B.; Chu, J.; Zhang, P. Silica in situ enhanced PVA/chitosan biodegradable films for food packages. Carbohydr. Polym. 2018, 184, 214–220. [Google Scholar] [CrossRef] [PubMed]
- Chen, X.; Taguchi, T. Enhanced Skin Adhesive Property of Hydrophobically Modified Poly(vinyl alcohol) Films. ACS Omega 2020, 5, 1519–1527. [Google Scholar] [CrossRef] [PubMed]
- Tripathi, S.; Mehrotra, G.; Dutta, P. Physicochemical and bioactivity of cross-linked chitosan–PVA film for food packaging applications. Int. J. Biol. Macromol. 2009, 45, 372–376. [Google Scholar] [CrossRef]
- Huang, H.; Huang, C.; Yin, C.; Khan, M.R.U.; Zhao, H.; Xu, Y.; Huang, L.; Zheng, D.; Qi, M. Preparation and characterization of β-cyclodextrin–oregano essential oil microcapsule and its effect on storage behavior of purple yam. J. Sci. Food Agric. 2020, 100, 4849–4857. [Google Scholar] [CrossRef]
- Çil, G.I.; Küplülü, Ö.; Cengiz, G.; Korkmaz, S.D.; Arslan, B.; Gürcan, S. Antibacterial activity of Turkish honey against selected foodborne pathogens. Ank. Üniversitesi Vet. Fakültesi Derg. 2020, 67, 413–418. [Google Scholar] [CrossRef]
- Roy, J.C.; Giraud, S.; Ferri, A.; Mossotti, R.; Guan, J.; Salaün, F. Influence of process parameters on microcapsule formation from chitosan—Type B gelatin complex coacervates. Carbohydr. Polym. 2018, 198, 281–293. [Google Scholar] [CrossRef]
- Piacentini, E.; Giorno, L.; Dragosavac, M.M.; Vladisavljevic, G.T.; Holdich, R.G. Microencapsulation of oil droplets using cold water fish gelatine/gum arabic complex coacervation by membrane emulsification. Food Res. Int. 2013, 53, 362–372. [Google Scholar] [CrossRef] [Green Version]
- Ang, L.F.; Darwis, Y.; Yee, L.; Yam, M.F. Microencapsulation Curcuminoids for Effective Delivery in Pharmaceutical Application. Pharmaceutics 2019, 11, 451. [Google Scholar] [CrossRef] [Green Version]
- Lee, A.R.; Han, C.H.; Yi, E. Preparation and characterization of melamine-formaldehyde microcapsules containing Citrus unshiu essential oil. Fibers Polym. 2014, 15, 35–40. [Google Scholar] [CrossRef]
- Liu, J.; Liu, C.; Liu, Y.; Chen, M.; Hu, Y.; Yang, Z. Study on the grafting of chitosan–gelatin microcapsules onto cotton fabrics and its antibacterial effect. Colloids Surf. B Biointerfaces 2013, 109, 103–108. [Google Scholar] [CrossRef] [PubMed]
- Nunes, C.N.; Emond, J.-P.; Fla State Hort, S. Relationship between Weight Loss and Visual Quality of Fruits and Vegetables. In Proceedings of the Annual Meeting of the Florida-State-Horticultural-Society, Palm Beach Gardens, FL, USA, 3–5 June 2007. [Google Scholar]
- Unal, H.; Akbudak, B. Some quality properties of three sweet cherry (Prunus avium L.) Cultivars during shelf life. Ital. J. Food Sci. 2008, 20, 391–399. [Google Scholar]
- Duhoranimana, E.; Karangwa, E.; Lai, L.; Xu, X.; Yu, J.; Xia, S.; Zhang, X.; Muhoza, B.; Habinshuti, I. Effect of sodium carboxymethyl cellulose on complex coacervates formation with gelatin: Coacervates characterization, stabilization and formation mechanism. Food Hydrocoll. 2017, 69, 111–120. [Google Scholar] [CrossRef]
- Tiernan, H.; Byrne, B.; Kazarian, S.G. ATR-FTIR spectroscopy and spectroscopic imaging for the analysis of biopharmaceuticals. Spectrochim. Acta Part A Mol. Biomol. Spectrosc. 2020, 241, 118636. [Google Scholar] [CrossRef] [PubMed]
- Staroszczyk, H.; Sztuka, K.; Wolska, J.; Wojtasz-Pająk, A.; Kołodziejska, I. Interactions of fish gelatin and chitosan in uncrosslinked and crosslinked with EDC films: FT-IR study. Spectrochim. Acta Part A Mol. Biomol. Spectrosc. 2014, 117, 707–712. [Google Scholar] [CrossRef]
- Mei, L.; Shi, L.; Song, X.; Liu, S.; Cheng, Q.; Zhu, K.; Zhuge, R. Characterization of Carboxymethyl Cellulose Films Incorporated with Chinese Fir Essential Oil and Their Application to Quality Improvement of Shine Muscat Grape. Coatings 2021, 11, 97. [Google Scholar] [CrossRef]
- Wang, J.; Li, J.; Li, S.; Freitag, C.; Morrell, J.J. Antifungal activities of Cunninghamia lanceolata heartwood extractives. Bioresources 2011, 6, 606–614. [Google Scholar] [CrossRef]
- Battisti, R.; Fronza, N.; Júnior Álvaro, V.; da Silveira, S.M.; Damas, M.S.P.; Quadri, M.G.N. Gelatin-coated paper with antimicrobial and antioxidant effect for beef packaging. Food Packag. Shelf Life 2017, 11, 115–124. [Google Scholar] [CrossRef]
- Mikkonen, K.S.; Heikkilä, M.I.; Helén, H.; Hyvönen, L.; Tenkanen, M. Spruce galactoglucomannan films show promising barrier properties. Carbohydr. Polym. 2010, 79, 1107–1112. [Google Scholar] [CrossRef]
- Kim, T.Y.; Song, E.H.; Kang, B.H.; Kim, S.J.; Lee, Y.-H.; Ju, B.-K. Hydrolyzed hexagonal boron nitride/polymer nanocomposites for transparent gas barrier film. Nanotechnology 2017, 28, 12LT01. [Google Scholar] [CrossRef] [PubMed]
- Shao, P.; Yu, J.; Chen, H.; Gao, H. Development of microcapsule bioactive paper loaded with cinnamon essential oil to improve the quality of edible fungi. Food Packag. Shelf Life 2021, 27, 100617. [Google Scholar] [CrossRef]
- Cai, C.; Ma, R.; Duan, M.; Deng, Y.; Liu, T.; Lu, D. Effect of starch film containing thyme essential oil microcapsules on physicochemical activity of mango. LWT-Food Sci. Technol. 2020, 131, 109700. [Google Scholar] [CrossRef]
- Yoon, S.-D.; Chough, S.-H.; Park, H.-R. Effects of additives with different functional groups on the physical properties of starch/PVA blend film. J. Appl. Polym. Sci. 2006, 100, 3733–3740. [Google Scholar] [CrossRef]
- Brodnjak, U.V. Experimental investigation of novel curdlan/chitosan coatings on packaging paper. Prog. Org. Coatings 2017, 112, 86–92. [Google Scholar] [CrossRef]
- Hassan, M.L.; Fadel, S.M.; Hassan, E.A. Acrylate/Nanofibrillated Cellulose Nanocomposites and Their Use for Paper Coating. J. Nanomater. 2018, 2018, 4953834. [Google Scholar] [CrossRef]
- Morsy, F.A.; El-Sherbiny, S. Mechanical properties of coated paper: Influence of coating properties and pigment Blends. J. Mater. Sci. 2004, 39, 7327–7332. [Google Scholar] [CrossRef]
- Masni-Azian, A.; Choudhury, I.A.; Sihombing, H.; Yuhazri, M.Y. Tensile Properties Evaluation of Paper Pulp Packaging at Different Sections and Orientations on the Egg Tray. In Proceedings of the International Conference on Advanced Materials Engineering and Technology (ICAMET 2012), Penang, Malaysia, 28–30 November 2012. [Google Scholar] [CrossRef]
- Lu, H.; Zhang, L.; Shi, Y.; Ma, J.; Zhou, X. Fabrication of Composite Ultrafiltration Membrane by Coating Urea Formaldehyde Resin on Filter Paper. Coatings 2020, 10, 482. [Google Scholar] [CrossRef]
- Storeck, A.; Batz-Sohn, C. Novel inkjet coating alumina. In Proceedings of the 2nd International Conference on Digital Fabrication Technologies, Denver, CO, USA, 17–22 September 2006. [Google Scholar]
- Jiang, Y.; Yu, L.; Hu, Y.; Zhu, Z.; Zhuang, C.; Zhao, Y.; Zhong, Y. The preservation performance of chitosan coating with different molecular weight on strawberry using electrostatic spraying technique. Int. J. Biol. Macromol. 2020, 151, 278–285. [Google Scholar] [CrossRef]
- Jongsri, P.; Wangsomboondee, T.; Rojsitthisak, P.; Seraypheap, K. Effect of molecular weights of chitosan coating on postharvest quality and physicochemical characteristics of mango fruit. LWT 2016, 73, 28–36. [Google Scholar] [CrossRef]
- Wszelaki, A. Effect of combinations of hot water dips, biological control and controlled atmospheres for control of gray mold on harvested strawberries. Postharvest Biol. Technol. 2003, 27, 255–264. [Google Scholar] [CrossRef]
- Shu, Z.J.; Liu, S.Q.; Yuan, Y.; Xia, Y.B. Quality Evaluation of Strawberries Packed with Perforated Film. In Proceedings of the International Conference on Packaging Technology and Science (ICPTS 2012), Chinese Soc Vibrat Engn, Comm Packag Dynam, Ningbo, China, 25–28 October 2012. [Google Scholar] [CrossRef]
- Ahmed, L.; Martin-Diana, A.B.; Rico, D.; Barry-Ryan, C. The impact of delactosed whey permeate treatment on shelf-life and antioxidant contents of strawberries. Int. J. Food Sci. Technol. 2012, 47, 1430–1438. [Google Scholar] [CrossRef]
- He, Y.; Bose, S.K.; Wang, W.; Jia, X.; Lu, H.; Yin, H. Pre-Harvest Treatment of Chitosan Oligosaccharides Improved Strawberry Fruit Quality. Int. J. Mol. Sci. 2018, 19, 2194. [Google Scholar] [CrossRef] [PubMed] [Green Version]
- Petriccione, M.; Mastrobuoni, F.; Pasquariello, M.S.; Zampella, L.; Nobis, E.; Capriolo, G.; Scortichini, M. Effect of Chitosan Coating on the Postharvest Quality and Antioxidant Enzyme System Response of Strawberry Fruit during Cold Storage. Foods 2015, 4, 501–523. [Google Scholar] [CrossRef] [Green Version]
- Aday, M.S.; Caner, C. The shelf life extension of fresh strawberries using an oxygen absorber in the biobased package. LWT 2013, 52, 102–109. [Google Scholar] [CrossRef]
- Wang, Y.; Zhang, J.; Cui, W.; Guan, C.; Mao, W.; Zhang, Z. Improvement in Fruit Quality by Overexpressing miR399a in Woodland Strawberry. J. Agric. Food Chem. 2017, 65, 7361–7370. [Google Scholar] [CrossRef] [PubMed]
- Hazarika, T.K.; Lalrinfeli; Lalthanmuani; Lalchhanmawia, J.; Mandal, D. Alteration of quality attributes and shelf-life in strawberry (Fragaria × ananassa) fruits during storage as influenced by edible coatings. Indian J. Agric. Sci. 2019, 89, 28–34. [Google Scholar]
Publisher’s Note: MDPI stays neutral with regard to jurisdictional claims in published maps and institutional affiliations. |
© 2022 by the authors. Licensee MDPI, Basel, Switzerland. This article is an open access article distributed under the terms and conditions of the Creative Commons Attribution (CC BY) license (https://creativecommons.org/licenses/by/4.0/).